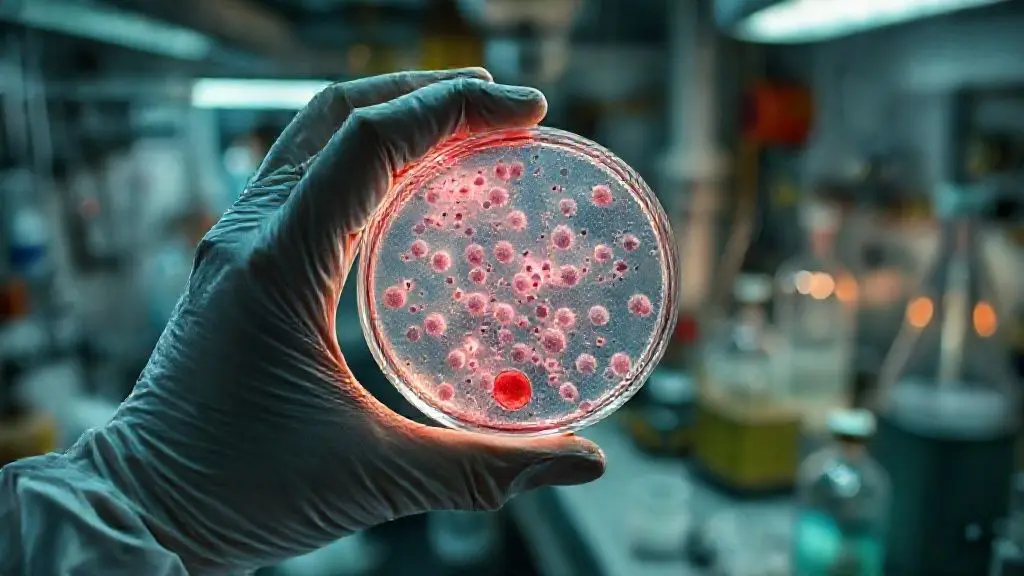
2. 감염의 시작: 재앙인가, 기적인가

1. 서론: 심해의 안개, 고립된 시추선에 드리운 미스터리
스코틀랜드 인근 해역, 원유 시추선 ‘브라보’호는 오늘도 분주하게 움직입니다. 하지만 최근 들어 통신이 자주 끊기고, 정체 모를 짙은 안개가 시추선을 감싸면서 작업자들 사이에는 미묘한 긴장감이 흐릅니다. 휴가를 앞둔 작업자들은 갑작스러운 본사의 헬기 지원 중단 소식에 불만을 터뜨리고, 책임자인 ‘메그너스’는 이들을 다독이며 작업을 이어가려 합니다. 하지만 이것은 거대한 미스터리의 시작에 불과했습니다. 마치 세상과 단절된 듯한 고립감 속에서, 하늘에서는 기묘한 화산재가 내리기 시작하며 불길한 서막을 알립니다.
2. 감염의 시작: 재앙인가, 기적인가
통신탑 수리를 위해 올랐던 작업자 ‘바지’가 추락하는 끔찍한 사고가 발생합니다. 모두가 그의 죽음을 예상했지만, 그는 몇 시간 만에 상처 하나 없이 멀쩡하게 깨어나는 기적을 보여줍니다. 하지만 그의 정신은 심각하게 불안정해지며 알 수 없는 환각과 목소리를 듣기 시작합니다. 연구원 ‘로즈’는 하늘에서 떨어진 재를 분석하던 중, 이 재가 단순한 화산재가 아닌 유기물에 기생하여 손상을 복구하고 불순물을 제거하는 고대의 포자(spore)임을 발견합니다. 이 포자는 상처를 통해 인체에 침투하며 숙주를 건강하게 만들지만, 동시에 그 정신을 잠식하기 시작합니다. 시추선에는 기적적인 치유와 함께 미지의 감염이 조용히 퍼져나가고 있었습니다.

3. 드러나는 진실: 고대 생명체와 거대한 음모
혼란이 가중되는 가운데, 본사 소속의 의문스러운 인물 ‘코크’가 나타나면서 시추선을 둘러싼 거대한 음모가 서서히 드러납니다. 사실 본사는 오래전부터 이 해저 단층에 고대의 박테리아, 즉 ‘선조’라 불리는 지적 생명체가 잠들어 있다는 사실을 알고 있었습니다. ‘프로젝트 K’라는 이름 아래 비밀리에 이 생명체를 연구하고 있었던 것입니다. 페름기 말부터 존재해 온 이 선조들은 인간의 시추 활동을 자신들에 대한 공격으로 간주하고, 포자를 퍼뜨려 자신들을 보호하려 했던 것입니다. 감염된 바지는 선조들의 기억과 목소리를 들으며 인간의 행동이 초래한 위험을 깨닫게 됩니다.

4. 선택의 기로: 공존과 파멸 사이에서
선조들은 인류가 지구에 위협이 된다고 판단하고, 거대한 쓰나미를 일으켜 모든 것을 태초로 되돌리려는 계획을 세웁니다. 이제 브라보호의 생존자들은 인류의 운명을 건 선택의 기로에 놓입니다. 코크는 인류를 위해 박테리아를 완전히 제거해야 한다고 주장하며 동료들의 희생도 마다하지 않는 냉혹한 모습을 보입니다. 반면, 로즈와 메그너스는 선조들과의 소통을 통해 공존의 가능성을 찾으려 합니다. 선조들과 연결된 바지는 인간의 잘못을 깨닫고 그들의 분노를 막기 위해 필사적으로 장비를 멈추려 하면서, 두 종족의 운명을 건 싸움이 시추선 내부에서 격렬하게 펼쳐집니다.

5. 결론: 끝나지 않은 위협과 인류의 미래
코크의 이기적인 계획으로 시추선은 폭발과 함께 붕괴하기 시작하고, 생존자들은 필사의 탈출을 감행합니다. 메그너스와 로즈를 포함한 몇몇은 구사일생으로 헬리콥터에 오르는 데 성공합니다. 하지만 간신히 살아남았다는 안도감도 잠시, 코크는 충격적인 사실을 밝힙니다. 이 모든 사태는 단순한 사고가 아니라, 박테리아의 존재를 세상에 알리고 확산시키려는 자신의 계획이었다는 것. 이미 안개와 화산재는 영국 본토를 향해 퍼져나가고 있으며, 브라보호의 사투는 인류 전체의 생존 투쟁의 시작일 뿐이라는 암시를 남기며 이야기는 막을 내립니다.